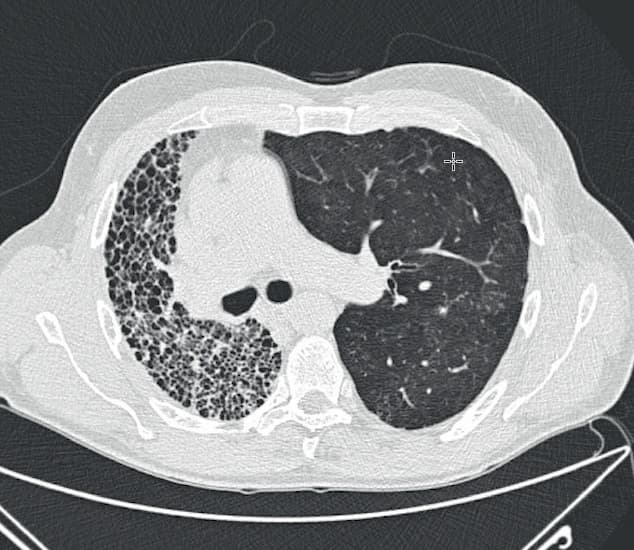
©. Enkeltlungetransplanteret patient med idiopatisk pulmonal fibrose. Til venstre ses den native lunge.

Aktuelt
Lungetransplantation gennem de sidste 25 år

©. Enkeltlungetransplanteret patient med idiopatisk pulmonal fibrose. Til venstre ses den native lunge.
10. apr. 2019
1 min.
Igennem de sidste 25 år er der foretaget over 750 lungetransplantationer i Danmark. Alle transplantationer foretages på Rigshospitalet, mens udredning af patienter foretages i samarbejde med universitetshospitalerne i Aarhus og Odense. Statusartiklen af Lund et al beskriver den historiske udvikling og gennemgår henvisningskriterierne, udredningsprocessen, selve operationen, den efterfølgende opfølgning, komplikationerne og langtidsprognosen.
Læs statusartiklen
De første 25 år med lungetransplantation i Danmark
Thomas Kromann Lund, Christian Holdflod Møller, Jesper Rømhild Davidsen et al